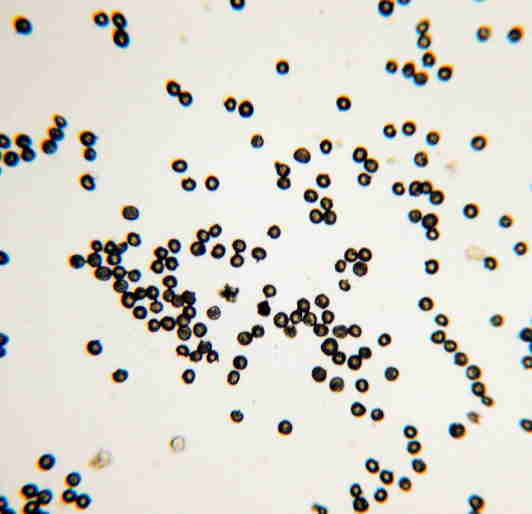

おもしろ自然写真館
いろんなミクロとおもしろい写真の世界をご覧下さい。
最近はなかなか顕微鏡撮影をやっている時間がありませんが
いろいろと考えて再度撮影に移りたいと思います。

おもしろ自然写真館
![]() このページは顕微鏡写真と自然写真の記事中心に構成しています。
このページは顕微鏡写真と自然写真の記事中心に構成しています。
いろんなミクロとおもしろい写真の世界をご覧下さい。
最近はなかなか顕微鏡撮影をやっている時間がありませんが
いろいろと考えて再度撮影に移りたいと思います。
 |
 |
 |
オオカメノキの芽出しの様子ですがいろんな形になる物です。実際に山で探してみてください。
左がバルタン星人、中がスターウォーズのヨーダ、右がヨーダの怒った顔。
 |
初雪の時に地面に積もった雪にアスファルトの気泡が出てきてふっくらと盛り上がった様子です。 とてもおもしろく写真には絶好の被写体でした。 |
 |
ポットホール
柔らかい土質の河床に丸い穴があくおもしろい現象です。
この丸い穴には中に石が入って回転するためにできるものです。
|
 |
左側はスギ花粉の拡大撮影です。花粉に小さな突起がついているのが判りますよ。
右側は水草の一種でヒメビシの実です。鋭くとがった実はまるで巻きビシみたいです。
こんなの踏んづけたらとんでもない痛みでしょうね。(T_T)
この写真は顕微鏡ではありませんが地元で見つかっている
化石の写真です。何の化石か判りますか??
 |
 |
約180万年前の魚沼層からみつかっています。
正解は一番下にありますよ。
◇◇◇◇◇◇◇◇◇◇◇◇◇◇◇◇◇◇◇◇◇◇◇◇◇◇◇◇◇◇◇◇◇◇◇◇◇◇◇◇◇
雪の結晶
 |
 |
 |
| 観察方法 | 1 観察に使う黒い紙、プラスチック類はあらかじめ冷蔵庫の冷凍庫などに入れておいて温度を下げておく事。 2 気温の低い日に降ってくる大粒の結晶を根気良く捜す事。 3 大き目のルーペを使用すると結晶の細部がよく観察できます。 4 バランスのとれた結晶は非常に数が少ないです。 5 観察の時に吐く息に注意(息が結晶に当たるとすぐに溶けてしまいます) 6 早朝が気温が低い為一番観察がしやすいですよ。 |
| 撮影方法 | 上記の結晶の撮影には50ミリマクロレンズに接写リング1、2、3号を使用して撮影 バックの紙は彩度の高いブルーの用紙を使用 フィルムはISO400のカラーネガフィルムにて撮影 ブレ防止のため三脚は必需品です。大型の方が安定しますよ。 |
◎◎◎◎◎◎◎◎◎◎◎◎◎◎◎◎◎◎◎◎◎◎◎◎◎◎◎◎◎◎◎◎◎◎◎◎◎◎◎◎◎◎◎◎◎◎◎◎
 |
 |
ミジンコ2態(顕微鏡40×での撮影です。)
池などはミジンコなどの微生物がたくさん生息しています。
熱帯魚用の網などですくうとたくさんのミジンコなどが網に
入ってきますよ。落ち葉などもすくうと更に種類が増えます。
(破裂したらこっぱみじんこ――(^_^;)ハハハッ )
◇◇◇◇◇◇◇◇◇◇◇◇◇◇◇◇◇◇◇◇◇◇◇◇◇◇◇◇◇◇◇◇◇◇◇◇◇◇◇◇◇◇◇◇◇◇◇◇◇◇◇◇◇◇◇◇
トンボの羽根の構造(顕微鏡40×での撮影です。)
 |
 |
アカトンボの仲間でノシメトンボの羽根の構造です。
ふちのギザギザや頑丈な骨格構造がわかりますよね
◆◆◆◆◆◆◆◆◆◆◆◆◆◆◆◆◆◆◆◆◆◆◆◆◆◆◆◆◆◆◆◆◆◆◆◆◆◆◆◆◆◆◆◆◆◆◆◆◆◆◆
化石の正体は左側が二枚貝、右側がカニです。
トップページに戻る